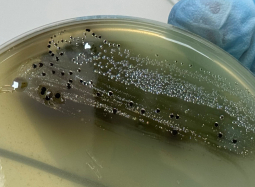

-
АВТО Эксперты выяснили, сколько бензина могут купить астраханцы за месяц
04.02.2026
Бензин – дорогое удовольствие?
-
Общество В Астраханской области поэтапно заменят двадцать старых котельных новыми
04.02.2026
Губернатор проверил работу новой котельной в микрорайоне 3-й Интернационал
-
Общество Росгвардейцы забрали у астраханских охотников оружие за многочисленные нарушения
04.02.2026
С владельцами оружия проведено около 1300 разъяснительных бесед
-
Общество В Астрахани оперативно решили проблему с канализацией после «Прямой линии»
04.02.2026
Сообщения астраханцев принимал вице-губернатор Денис Афанасьев
-
Общество Муниципалитет хотел возместить укус собаки из бюджета Астраханской области
04.02.2026
Кассация: муниципалитеты несут ответственность за безнадзорных животных
-
Происшествия Оренбуржцы силой поместили астраханца в машину и пытались увезти из региона
04.02.2026
Группу похитителей остановили в центральной части Астраханской области
-
Общество Губернатор: астраханцам должны сообщать всю информацию о коммунальных авариях
04.02.2026
Кстати, количество аварий уменьшилось на 40%
-
Общество Астраханские росгвардейцы два дня подряд ловят нарушителей в крупных магазинах
03.02.2026
Им даже попался мужчина из федерального розыска
-
Происшествия Астраханку ждет суд за сбитую на пешеходном переходе пенсионерку
03.02.2026
Женщина-водитель не убедилась в безопасности своего маневра
-
Общество Астраханские коммунальщики готовятся к очередной порции снега и льда
03.02.2026
Уже усилены работы по очистке тротуаров


Астрахань
Пятница, 03 апреля